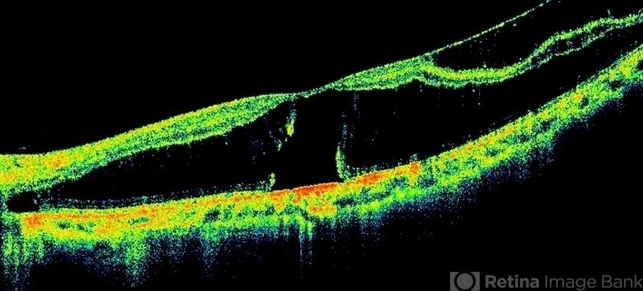
file

-
 By Mallika Goyal, MD
By Mallika Goyal, MD
Apollo Health City - Uploaded on Feb 11, 2016.
- Last modified by Caroline Bozell on Feb 11, 2016.
- Rating
- Appears in
- Miscellaneous
- Condition/keywords
- myopic foveoschisis
- Description
- Left eye OCT of a 22-year-old lady with myopic foveoschisis & an outer lamellar macular hole who presented with complaint of Left Eye vision drop 4 months prior to presentation. BCVA was 20/400. The lamellar macular hole accounts for the vision loss.

Initializing download.
Initializing download.---thumb.jpg/image-square;max$79,0.ImageHandler)
---thumb.jpg/image-square;max$79,0.ImageHandler)




